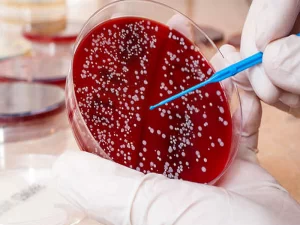
کاربردهای پیوند مغز استخوان در نقص ایمنی

روش های تشخیص بیماری نقص ایمنی
روش های تشخیص بیماری نقص ایمنی شامل چه مواردی میشود؟ روش های مختلفی برای تشخیص بیماری های نقص ایمنی وجود دارد که با ضعف یا
موسسه خیریه بیماران نقص ایمنی » مقالات

روش های تشخیص بیماری نقص ایمنی شامل چه مواردی میشود؟ روش های مختلفی برای تشخیص بیماری های نقص ایمنی وجود دارد که با ضعف یا

علائم هشدار دهنده در بیماران نقص ایمنی چیست؟ بیماران مبتلا به اختلالات نقص ایمنی ممکن است با علائم و نشانههای هشداردهنده مختلفی مراجعه کنند که

بیماری نقص ایمنی و پوست چه ارتباطی با یکدیگر دارند؟ یکی از وظایف اولیه سیستم ایمنی در رابطه با پوست محافظت در برابر عوامل بیماری

بیماری نقص ایمنی و عفونت چه ارتباطی با یکدیگر دارند؟ سیستم ایمنی نقش مهمی در محافظت از بدن در برابر عوامل بیماری زا مانند باکتری
اختلالات نقص ایمنی گروهی از شرایط است که در آن سیستم ایمنی قادر به محافظت موثر از بدن در برابر مهاجمان خارجی مانند باکتری ها،

عوامل محیطی و بیماریهای نقص ایمنی چه ارتباطی با یکدیگر دارند؟ بیماری های نقص ایمنی، گروهی از اختلالات هستند که در آن سیستم ایمنی قادر

مقایسه روشهای مختلف اهدای سلولهای بنیادی در درمان نقص ایمنی یکی از موضوعاتی است که امروزه به آن به صورت تخصصی پرداخته میشود. اختلالات نقص

اهدای سلولهای بنیادی به بیماران نقص ایمنی امکان دارد؟ پیوند سلول های بنیادی به عنوان یک گزینه درمانی امیدوارکننده برای این بیماران پدیدار شده است

بیماری نقص ایمنی و دستگاه گوارش چه ارتباطی با یکدیگر دارند؟ اختلالات گوارشی که بر دهان، گلو، معده و روده تأثیر میگذارد، در بسیاری از

طبقه بندی بیماری های نقص ایمنی اولیه به چه صورت است؟ بیماری های نقص ایمنی اولیه گروهی از اختلالات هستند که با نقص در سیستم